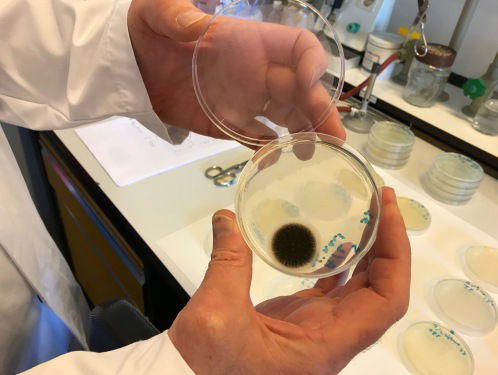
Onze Radio 1-plopkappen zitten vol bacteriën en schimmels

Overzicht
Fragmenten
- Nieuws en CoNOS/NTR
Cultuur: VanWyck
- Nieuws en CoNOS/NTR
Live muziek: VanWyck
- Nieuws en CoNOS/NTR
VMBO deel 2
- Nieuws en CoNOS/NTR
Onze Radio 1-plopkappen zitten vol bacteriën en schimmels
- Nieuws en CoNOS/NTR
VMBO deel 1
- EenVandaagAVROTROS
Column Jasper van Kuijk over raadsleden
- EenVandaagAVROTROS
Politiek Café met Jan Paternotte (D66) en Marjan Minnesma (Urgenda)
- De Nieuws BVBNNVARA
GeenStijl een geschiedenisles
- De Nieuws BVBNNVARA
De weddenschap
- De Nieuws BVBNNVARA
Wild Wild Country: de bijzondere geschiedenis van de Bhagwanbeweging
- De Nieuws BVBNNVARA
Druktemaker Kees van Amstel - Heerlijk die lijdensweg!
- De Nieuws BVBNNVARA
Het Allermooiste - Meisterlijk Proza
- De Nieuws BVBNNVARA
Wat als je DNA opduikt in een liquidatiezaak? Met Geert-Jan Knoops en Timme Dankers
- 1 op 1KRO-NCRV
Wat is de toekomst van het roken? Een scherp gesprek met de tabaksindustrie zelf
- SpraakmakersKRO-NCRV
Gezond verstand
- SpraakmakersKRO-NCRV
Vitaal oud worden; heb je dat zelf in de hand?
- SpraakmakersKRO-NCRV
Gezond leven in een digitale wereld
- SpraakmakersKRO-NCRV
Gezond eten; hoe doe je dat in een tijd van voedselhypes?
- SpraakmakersKRO-NCRV
Het Taalteam met Frank van Pamelen
- SpraakmakersKRO-NCRV
Hoe zie je als nieuwsconsument de bomen nog door het bos van gezondheidsnieuws?
- SpraakmakersKRO-NCRV
Stand.nl: We weten zelf het beste wat goed is voor onze gezondheid
- NOS Radio 1 JournaalNOS
Bits of Freedom niet tevreden met aanpassingen inlichtingenwet
- Nooit Meer SlapenVPRO
De Reismicrofoon: actrice Saskia Huybrechtse
- Nooit Meer SlapenVPRO
Open Kaart: Multigroove oprichter Ilja Reiman
- Nooit Meer SlapenVPRO
Schrijver Auke Hulst over de donderdag die was
- Nooit Meer SlapenVPRO
Beeldend kunstenaar Jan Henderikse maakt iets van niets
- NOS Met het Oog op MorgenNOS
Voorstelling over een populaire Eurocommissaris
- NOS Met het Oog op MorgenNOS
Hoe moet het verder met de Oostvaardersplassen?
- NOS Met het Oog op MorgenNOS
AMC maakt duur medicijn gewoon zelf
- NOS Met het Oog op MorgenNOS
Den Haag Vandaag: wiv wordt aangepast
- Langs de Lijn En OmstrekenEO/NOS
Diederik Live: Sleepwet toch aangepast
- Langs de Lijn En OmstrekenEO/NOS
Ruzies, twijfels, volwassen worden; Lady Bird IS perfecte coming of age film
- Langs de Lijn En OmstrekenEO/NOS
Ontmoet Tessa, de sociale robot, met een bloempot op haar hoofd
- Langs de Lijn En OmstrekenEO/NOS
Bioloog Jelle Reumer: Corridor nodig bij Oostvaardersplassen
- Langs de Lijn En OmstrekenEO/NOS
Reinout Meijer ontmoet kampoverlever Wim Aloserij
- Langs de Lijn En OmstrekenEO/NOS
Tom Egbers blij met naamsverandering: het was al een tijdje gênant
- Langs de Lijn En OmstrekenEO/NOS
GroenLinks blij met aanpassing WIV
- KunststofNTR
Femke Halsema, schrijver en oud-politicus
- Bureau BuitenlandVPRO
De verkiezingen in Mexico en het Trump-effect
- Bureau BuitenlandVPRO
Hoorzitting nieuwe CIA-directeur